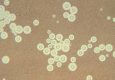
None

[Rare superinfection in a COVID-19 patient-A chronology]
- PMID: 34427689
- PMCID: PMC8383027
- DOI: 10.1007/s00101-021-01018-2
[Rare superinfection in a COVID-19 patient-A chronology]
Abstract
After a resuscitation situation a SARS-CoV‑2 sample from a 55-year-old man who had been in the hospital for elective ablation for atrial fibrillation was tested positive. The patient history revealed that there had been a previous confirmed contact with a COVID-19 positive patient. The patient developed the complete set of symptoms of COVID-19 pneumonia with extensive intensive care treatment. After about 2 weeks of treatment, weaning had to be stopped due to the deterioration of the severe septic condition of the patient and he showed microbiological evidence of a superinfection with Cryptococcus neoformans and later Leclercia adecarboxylata. The patient was treated successfully and survived the disease.
Bei einem 55-jährigen Mann, der sich zur elektiven Ablation bei Vorhofflimmern in der Klinik befand, wurde nach einer Reanimationssituation auf der peripheren Station ein SARS-CoV-2-Abstrich positiv getestet. Anamnestisch gab es im Vorwege gesicherten Kontakt zu einem COVID-19-positiven Patienten. Im Verlauf entwickelte sich das Vollbild einer COVID-19-Pneumonie mit umfangreicher intensivmedizinischer Behandlung. Nach rund 2‑wöchiger Therapie musste das Weaning bei erneuter Verschlechterung abgebrochen werden, und es ergaben sich bei dem wiederholt hochseptischen Patienten mikrobiologische Nachweise einer Superinfektion mit Cryptococcus neoformans und später Leclercia adecarboxylata. Der Patient wurde erfolgreich behandelt und überlebte die Erkrankung.
Keywords: ARDS; Cryptokokkus neoformans; Leclercia adecarboxylata; SARS-CoV-2; Sepsis.
© 2021. Springer Medizin Verlag GmbH, ein Teil von Springer Nature.
References
-
- S3-Leitlinie Invasive Beatmung und Einsatz extrakorporaler Verfahren bei akuter respiratorischer Insuffizienz, AWMF Leitlinien-Register Nummer 001/021, Stand 4. Dez. 2017
-
- S3-Leitlinie Behandlung von erwachsenen Patienten mit ambulant erworbener Pneumonie und Prävention – Update 2016, AWMF Leitlinien-Register Nummer 020/020, Stand 31. Dez. 2015 (zurzeit in Revision)
-
- S3-Leitlinie Epidemiologie, Diagnostik und Therapie erwachsener Patienten mit nosokomialer Pneumonie, AWMF Leitlinien-Register Nummer 020/013, Stand 11. Sept. 2017
Publication types
MeSH terms
LinkOut - more resources
Full Text Sources
Medical
Miscellaneous